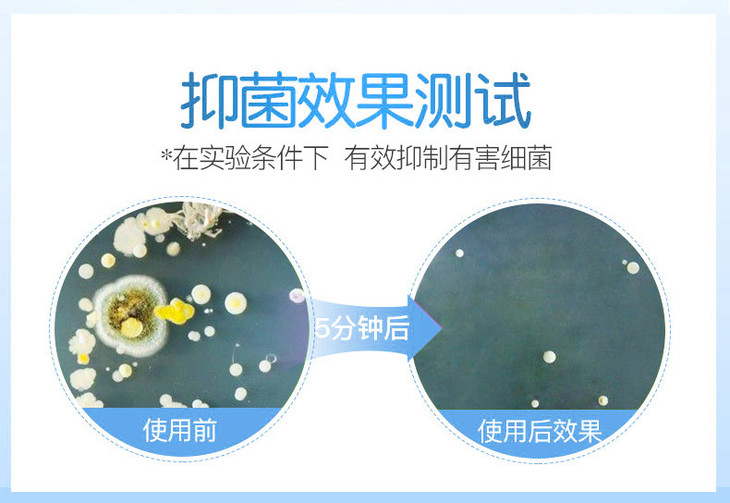

【内衣专洗液】茵芭内衣裤洗衣凝露洗衣液 95%天然用材抑jun率99.9%去血渍去污渍去异味 男女可用
¥49.00 - 98.00
| 运费: | ¥ 0.00-15.00 |
| 库存: | 125632 件 |
商品详情

- 遇荐良品 (微信公众号认证)
- 专业的管理团队,时刻以顾客的利益为主,同类的商品更有竞争力,遇见我们,就是遇荐良品!
- 扫描二维码,访问我们的微信店铺
- 随时随地的购物、客服咨询、查询订单和物流...